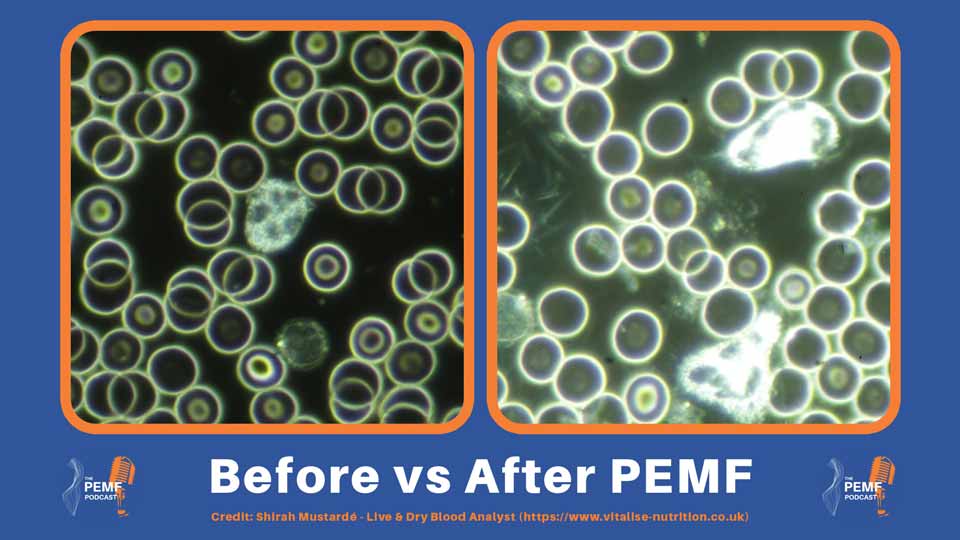
White blood cells shown before and after PEMF therapy

Joshua Roberts 10:02
Yeah, as you say, it is quite striking the difference between the two blood samples. If you're watching, you'll be able to see it is quite a pale kind of reddish color and then it is almost quite a bright, red, intense color. And if you're listening, they were the major kind of two differences. But really for PEMF and oxygenation, how does it actually achieve this result?
Andy Smith 10:21
So one of the biggest reasons PEMF helps with oxygenation is its effect on blood vessel behavior, especially the tiny micro vessels that control how easily blood can flow through tissues. A key part of this is nitric oxide, specifically endothelial nitric oxide, which is produced by the cells lining your blood vessels. Nitric oxide is a natural vasodilator, meaning it tells the vessels to relax and widen. When vessels open even slightly, blood can move more freely and oxygen delivery becomes more efficient. There's an interesting animal study that demonstrates this. Researchers applied a PEMS signal directly to the creemaster muscle of rats and observed the anteriolas, the very small vessels that control blood flow into tissues. What they saw was rapid and measurable vasodilation. Within just two minutes, the vessels widened by about nine percent, and after an hour of stimulation, the dilation remained almost identical. Importantly, nothing else changed. The rat's heart rate, blood pressure and tissue temperature stayed the same. So the vessel widening wasn't caused by heat or stress. It was a direct local effect of the PEMF signal on the microvasculature. This kind of vasodilation ties back to the nitric oxide signaling. PEMF has been shown in various studies to influence endothelial function, helping the vessel walls release more nitric oxide. When that happens, the vessels relax, circulation improves, and oxygen can move into tissues with far less resistance. So when we see blood samples shift from pale to richer red after the PEMF session, this microvascular response helps explain why it's not just the cells themselves, it's the delivery system. Wider vessels plus smoother flow means more oxygen is able to reach the tissues effectively, which lines up with what we've seen visually in that blood work.
Joshua Roberts 12:29
Yeah, so we now know the PEMF can help with vasodilation, helping the blood vessels actually get wider, but can that actually help support them in any other way?
Andy Smith 12:38
Yeah, this is a fascinating area, actually. There was a study that looked at how PEMF affects angiogenesis, which is the process of forming new blood vessels, something the body relies on heavily when it's healing or repairing tissue. Researchers used human endothelial cells and exposed them to a PEMF signal at around, well, sorry, strength around 40 gauss and 80 hertz frequency. They saw that the cells became much better that are growing and forming new vessel structures. But the really interesting part is how it happened. PEMF actually shifted the way those cells produced energy. Normally, endothelial cells rely on a mix of mitochondrial respiration and glycolysis, but respiration can generate a lot of reactive oxygen species, basically cellular exhaust fumes that can limit healing. Under PEMF, the cells switched towards cleaner, faster glycolysis, which reduced oxidative stress and gave them more usable energy. They also noticed changes inside the mitochondria themselves. The PEMF triggered mitochondrial fission, which is a normal adjustment the cell makes to stay energized and healthy. This shift is mitochondrial behavior helped the cells stay in optimal state of growth and repair. So overall, the study suggests that PEMF doesn't just help vessels open up. It may also help the body build new micro vessels, which is a huge part of how tissues restore oxygen, nutrients and proper circulation.
Joshua Roberts 14:16
Yeah, no, that's great. And this just shows that PEMF doesn't actually just affect the blood itself, actually affects how the blood is transported and the roots of transport almost. But we've spoken a lot in this episode about red blood cells, but there are also white blood cells. Did we have any blood analysis for this?
Andy Smith 14:34
Yeah, absolutely. And this part was actually really interesting. When she relates at the white blood cells before and after PMF, there were only a few visible in the sample. And the ones that were there seemed almost quite static. They weren't really moving or interacting with their environment, which can be a sign that they're not particularly energised or active. After the PEMF session, the picture was completely different. There were noticeably more white blood cells visible in the sample, but the biggest change was their behaviour. They were moving with far more energy and purpose, and you could actually see them roaming across the slide, changing shape, and doing what healthy white blood cells are supposed to do. That increase in motility is often interpreted as a sign of better activity and responsiveness. So while most people talk about PEMF and red blood cells, the white blood cell side of things is just as fascinating, because it gives you a glimpse into how PEMF might support general cellular activity and immune function on a micro level.